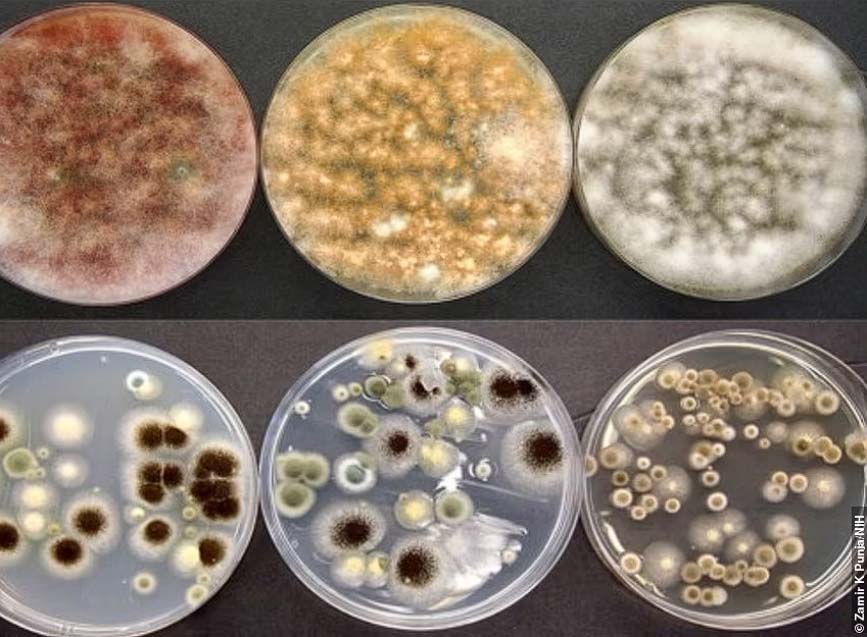

As South Africa’s cannabis industry expands, ensuring product safety and quality is critical. With cannabis now being cultivated for medical, wellness, and commercial use, concerns around contamination from mould, bacteria, and heavy metals are growing.
Thank you for reading this post, don't forget to subscribe!Globally, reports have revealed that even legally sold cannabis in regulated markets can be tainted with dangerous contaminants, putting consumers—especially medical cannabis patients—at risk. South Africa is no exception, and as the local industry develops, implementing proactive contamination control measures is essential to prevent health risks, financial losses, and regulatory failures.
In this article, we examine the threats posed by cannabis contamination, the challenges of ensuring purity in the local market, and how Bactraban’s antimicrobial solutions — AEGIS® and On & Gone™—can help safeguard South Africa’s cannabis industry.
The Growing Risk of Contaminated Cannabis in South Africa
1. The Reality of Cannabis Contaminants
While South Africa’s legal cannabis industry is still developing, contamination risks mirror global challenges. International studies have found dangerous levels of mould, bacteria, pesticides, and heavy metals in cannabis, even in regulated markets.
South Africa’s hot and humid climate creates the perfect breeding ground for microbial contamination, making proactive prevention essential.
Common contaminants found in cannabis include:
- Mould & Fungi: Aspergillus and Penicillium — linked to lung infections and respiratory diseases.
- Bacteria: E. coli and Salmonella — can cause serious stomach infections.
- Heavy Metals: Cannabis absorbs lead, mercury, and cadmium from soil, leading to long-term health risks.
- Pesticide Residues: Many growers use chemicals that leave behind harmful toxic traces in the final product.
2. Cannabis Testing Challenges & Consumer Risk
Despite efforts to regulate medical cannabis, testing procedures remain inconsistent, and many illicit market products remain untested.
The lack of strict microbial and heavy metal testing laws means that tainted products can still reach consumers, putting medical patients, recreational users, and export markets at risk.
Without stringent safety protocols:
- Mould and bacteria can thrive on stored cannabis products.
- Growers risk entire crop losses due to microbial contamination.
- South Africa’s cannabis exports could face international rejection due to contamination concerns.
With global markets requiring strict microbial safety standards, South Africa’s cannabis industry must adopt advanced contamination control strategies to remain competitive.
Mold samples taken from marijuana plants. The petri dishes on the left show evidence of Fusarium – a large genus of filamentous fungi linked the cannabis plant, as well as the toxins they produce. Image Credit: Zamir K Punja NIH
Bactraban’s Solution: Protecting South Africa’s Cannabis Industry
While laboratory testing helps identify contaminated products, the best strategy is preventing contamination from happening in the first place. This is where Bactraban’s antimicrobial technologies come in.
1. AEGIS® Microbe Shield: Advanced Antimicrobial Surface Protection
AEGIS® is a game-changing antimicrobial technology that provides long-term protection against mould, bacteria, and fungi on cannabis-related surfaces.
Unlike traditional disinfectants that only work when applied, AEGIS® bonds to surfaces permanently, preventing microbial growth between cleaning cycles.
- Prevents mould and bacteria growth – Creates an inhospitable environment for microbes.
- Binds to all surfaces – Ideal for grow rooms, packaging facilities, dispensaries, and transport containers.
- Non-toxic and safe for cannabis environments – Does not leach chemicals or affect plant quality.
- Long-lasting protection – Works for months, not hours, unlike traditional disinfectants.
Applying AEGIS® to cannabis growing and processing facilities ensures that surfaces remain protected from contamination, reducing the risk of tainted products reaching the market.
2. On & Gone™: The Fastest Mould Stain Remover for Cannabis Cultivation
Mould is one of the biggest threats to cannabis crops in South Africa’s warm climate. On & Gone™ is a fast-acting mould stain remover that eliminates visible and hidden fungal growth in greenhouses, drying rooms, and storage areas.
- Instantly removes mould stains – Eliminates visible fungal growth from surfaces.
- Deep penetration formula – Unlike bleach, On & Gone™ reaches deep into porous surfaces to remove hidden mould spores.
- Works in combination with AEGIS® – After On & Gone™ cleans a surface, AEGIS® can be applied to prevent regrowth.
For cannabis farmers, combining On & Gone™ with AEGIS® provides an all-in-one solution for preventing contamination and ensuring compliance with safety standards.
How Bactraban’s Solutions Benefit South Africa’s Cannabis Industry
To compete in the global medical and recreational cannabis markets, South Africa must prioritise safety and microbial control.
Where AEGIS® and On & Gone™ Make the Biggest Impact:
Grow Rooms & Greenhouses – Prevents mould outbreaks that can destroy crops.
- Processing & Packaging Facilities – Keeps surfaces and storage containers microbe-free.
- Dispensaries & Storage Units – Protects packaged cannabis from contamination.
- Cannabis Export Facilities – Helps South African producers meet international safety standards.
- HVAC & Air Filtration Systems – Reduces airborne mould spores, ensuring a clean and compliant environment.
By incorporating AEGIS® and On & Gone™, South African cannabis businesses can protect their crops, improve product safety, and gain a competitive edge in the global market.
Conclusion: A Safer Future for South Africa’s Cannabis Industry
As South Africa’s cannabis industry grows, so do the risks associated with contaminated products. Fungal, bacterial, and heavy metal contamination threaten both consumers and businesses, making proactive antimicrobial defence a necessity.
By implementing Bactraban’s AEGIS® and On & Gone™ solutions, cannabis growers, processors, and dispensaries can:
- Prevent microbial contamination before it happens.
- Ensure compliance with local and international safety standards.
- Deliver safer, cleaner cannabis products to consumers.
- Protect crops and reduce financial losses due to mould infestations.
South Africa has the potential to become a leader in the global cannabis market, but only if product safety remains a priority. Bactraban’s proven antimicrobial solutions offer the most effective way to safeguard the future of the industry.
Want to ensure your cannabis operation stays clean, safe, and compliant?
Contact Bactraban today to learn more about how AEGIS® and On & Gone™ can protect your facility.